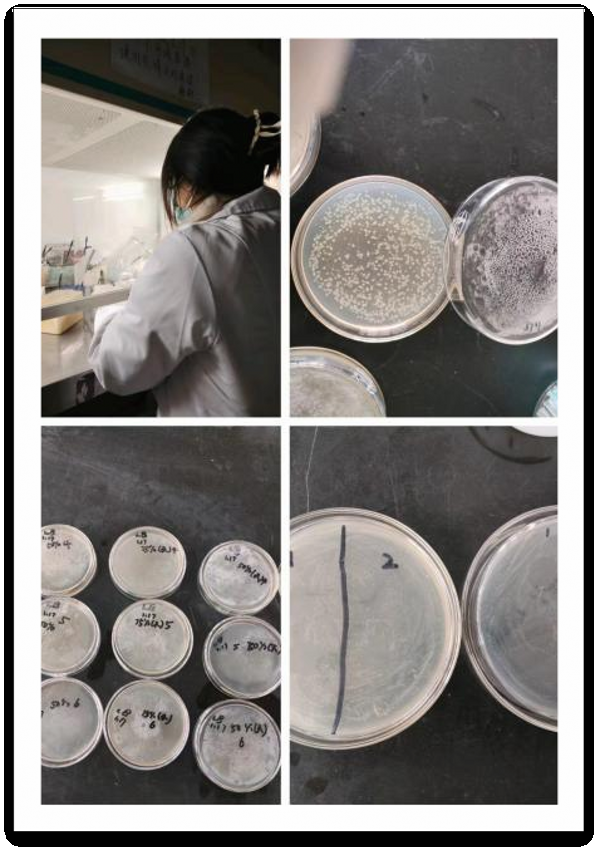

自2021年起,为了抢救性保护中国手工纸造纸技艺,西南科技大学“藏韵纸艺”团队在该校钟一鸣老师的带领下,参与到中国科学技术大学汤书昆教授的全国手工纸调研项目中。该团队由西南科技大学数理学院成立,涵盖信息与计算科学、生物工程、应用物理、数据科学与大数据技术、汉语国际教育等多个专业学生,致力于中国手工造纸技艺的保护与传承。
在西南地区手工纸的调研过程中,团队结缘了一种独特的存在——藏纸。藏纸作为中国手工纸品类中独特的存在,具有纹理清晰、质感极佳、防虫蛀鼠咬、千年不腐等特点,还凝结着藏传佛教的神秘色彩与民族信仰。然而,通过深入藏区实地调研、与多位藏纸传承人的交流,团队发现藏纸面临着传承与发展的困境,如造纸工艺原始、生产规模受限导致价格居高不下,以及使用场景单一、市场受众狭窄等问题。


团队深入藏区调研图片与证明材料
为了改变这一现状,以理工科背景为主的学生团队利用专业优势,采取了一系列积极行动。他们借助本校国家级生物质材料研究中心的实验平台,对藏纸进行实验分析。具体包含,通过水滴法和侵泡法观察其抗水性,借助材料分测中心SEM扫描电镜进行纤维表面形貌成像和成分分析,验证了其优越的抗水性和抗老化性;通过GB15979规定的抑菌法对藏纸进行生长性能和存活率分析对藏纸进行液相色谱LC分析,验证了藏纸防虫耐霉的特点;开展共32次的急性毒性评价、数次细胞存活率分析和细胞成像实验,验证原料微毒性对人体接触的安全性。
图2团队成员对藏纸进行理化性能分析

图3藏纸纤维表面成像图

图4行液相色谱LC分析结果

图5细胞急性毒性成像
同时,通过田野调研获取的一手资料,该团队建立了包含8余种藏域不同类别藏纸的数据库,并通过数据对比掌握了藏纸优势性能与原料品类、产地、用量的关联性,从而找到了生产优质新型藏纸的配料参数,实现了技术赋能质量。此外,该团队结合现代造纸工艺与传统工艺产能的缺陷,与波密藏纸传承人索朗旺久沟通交流,参与优化改进藏纸生产线。在创新方面,推出了“纸短情长”、“传家宝”、“祈福藏韵”三个文创系列,目前正在积极申请专利。

图6三款文创产品
“藏韵纸艺”团队的努力展示了年轻一代对藏纸乃至中华传统文化传承的使命感,他们以科技与文化双赋能,致力于实现传统与未来的共同发展,让藏纸这一非遗文化得以延续和传承。科技与文化双赋能,传统与未来共发展;愿藏纸不止,非遗不遗。(岳斌)
客户端
媒体矩阵
企业邮箱